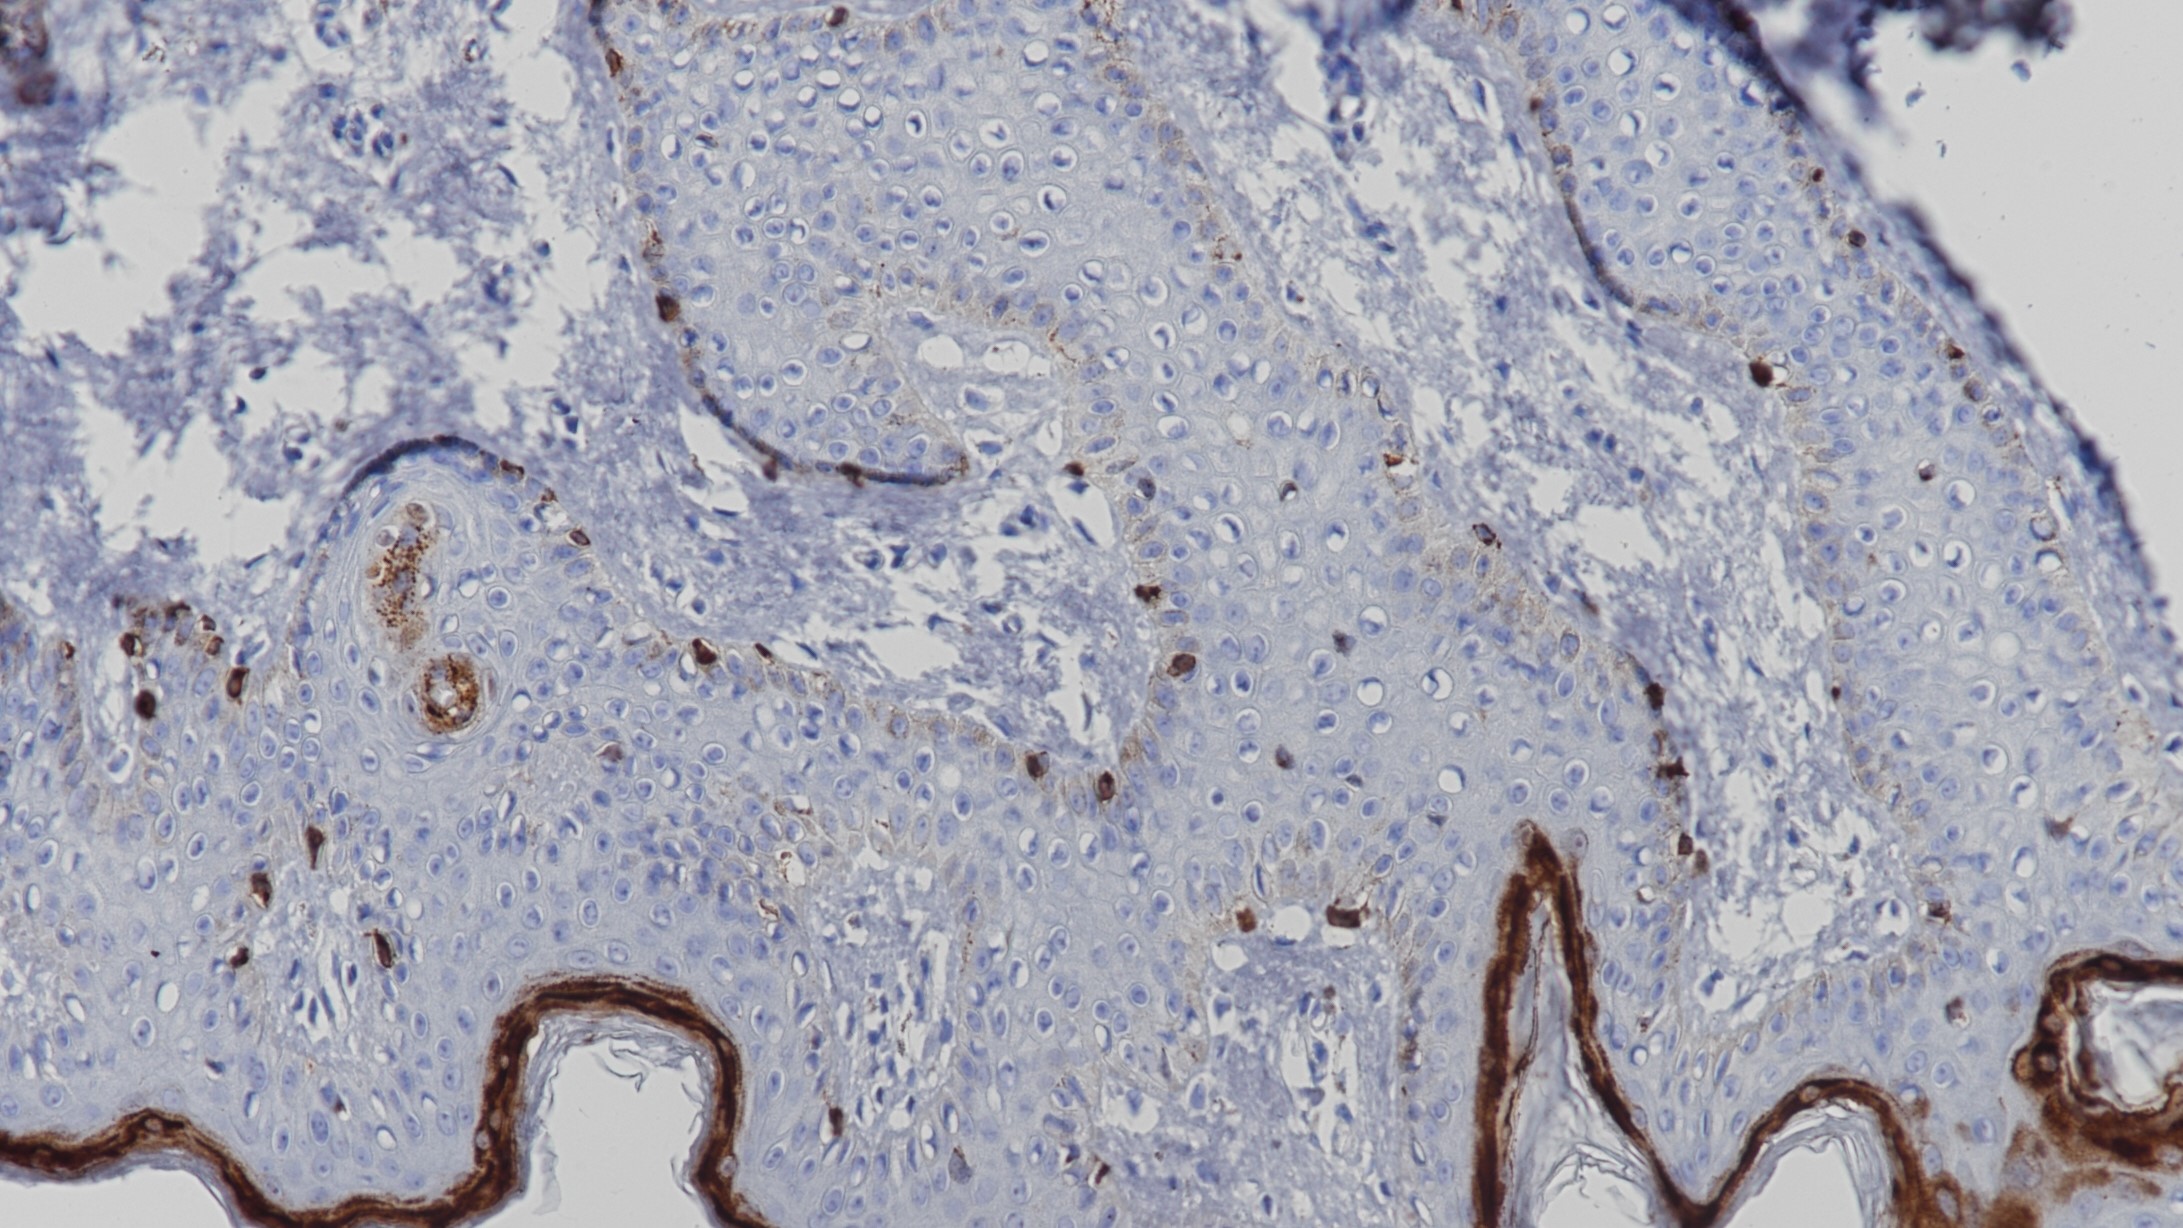
皮肤Melan-A(BP6086)染色

1. Jungbluth A A , Busam K J , Gerald W L , et al. A103: An anti-melan-a monoclonal antibody for the detection of malignant melanoma in paraffin-embedded tissues[J]. American Journal of Surgical Pathology, 1998, 22(5):595-602.
2. Busam K . Expression of Melan-A (MART 1) in benign melanocytic nevi and primary cutaneous malignant melanoma[J]. Am J Surg Pathol, 1998, 22.
3.中华医学会.《临床技术操作规范·病理学分册》.人民军医出版社,2004.